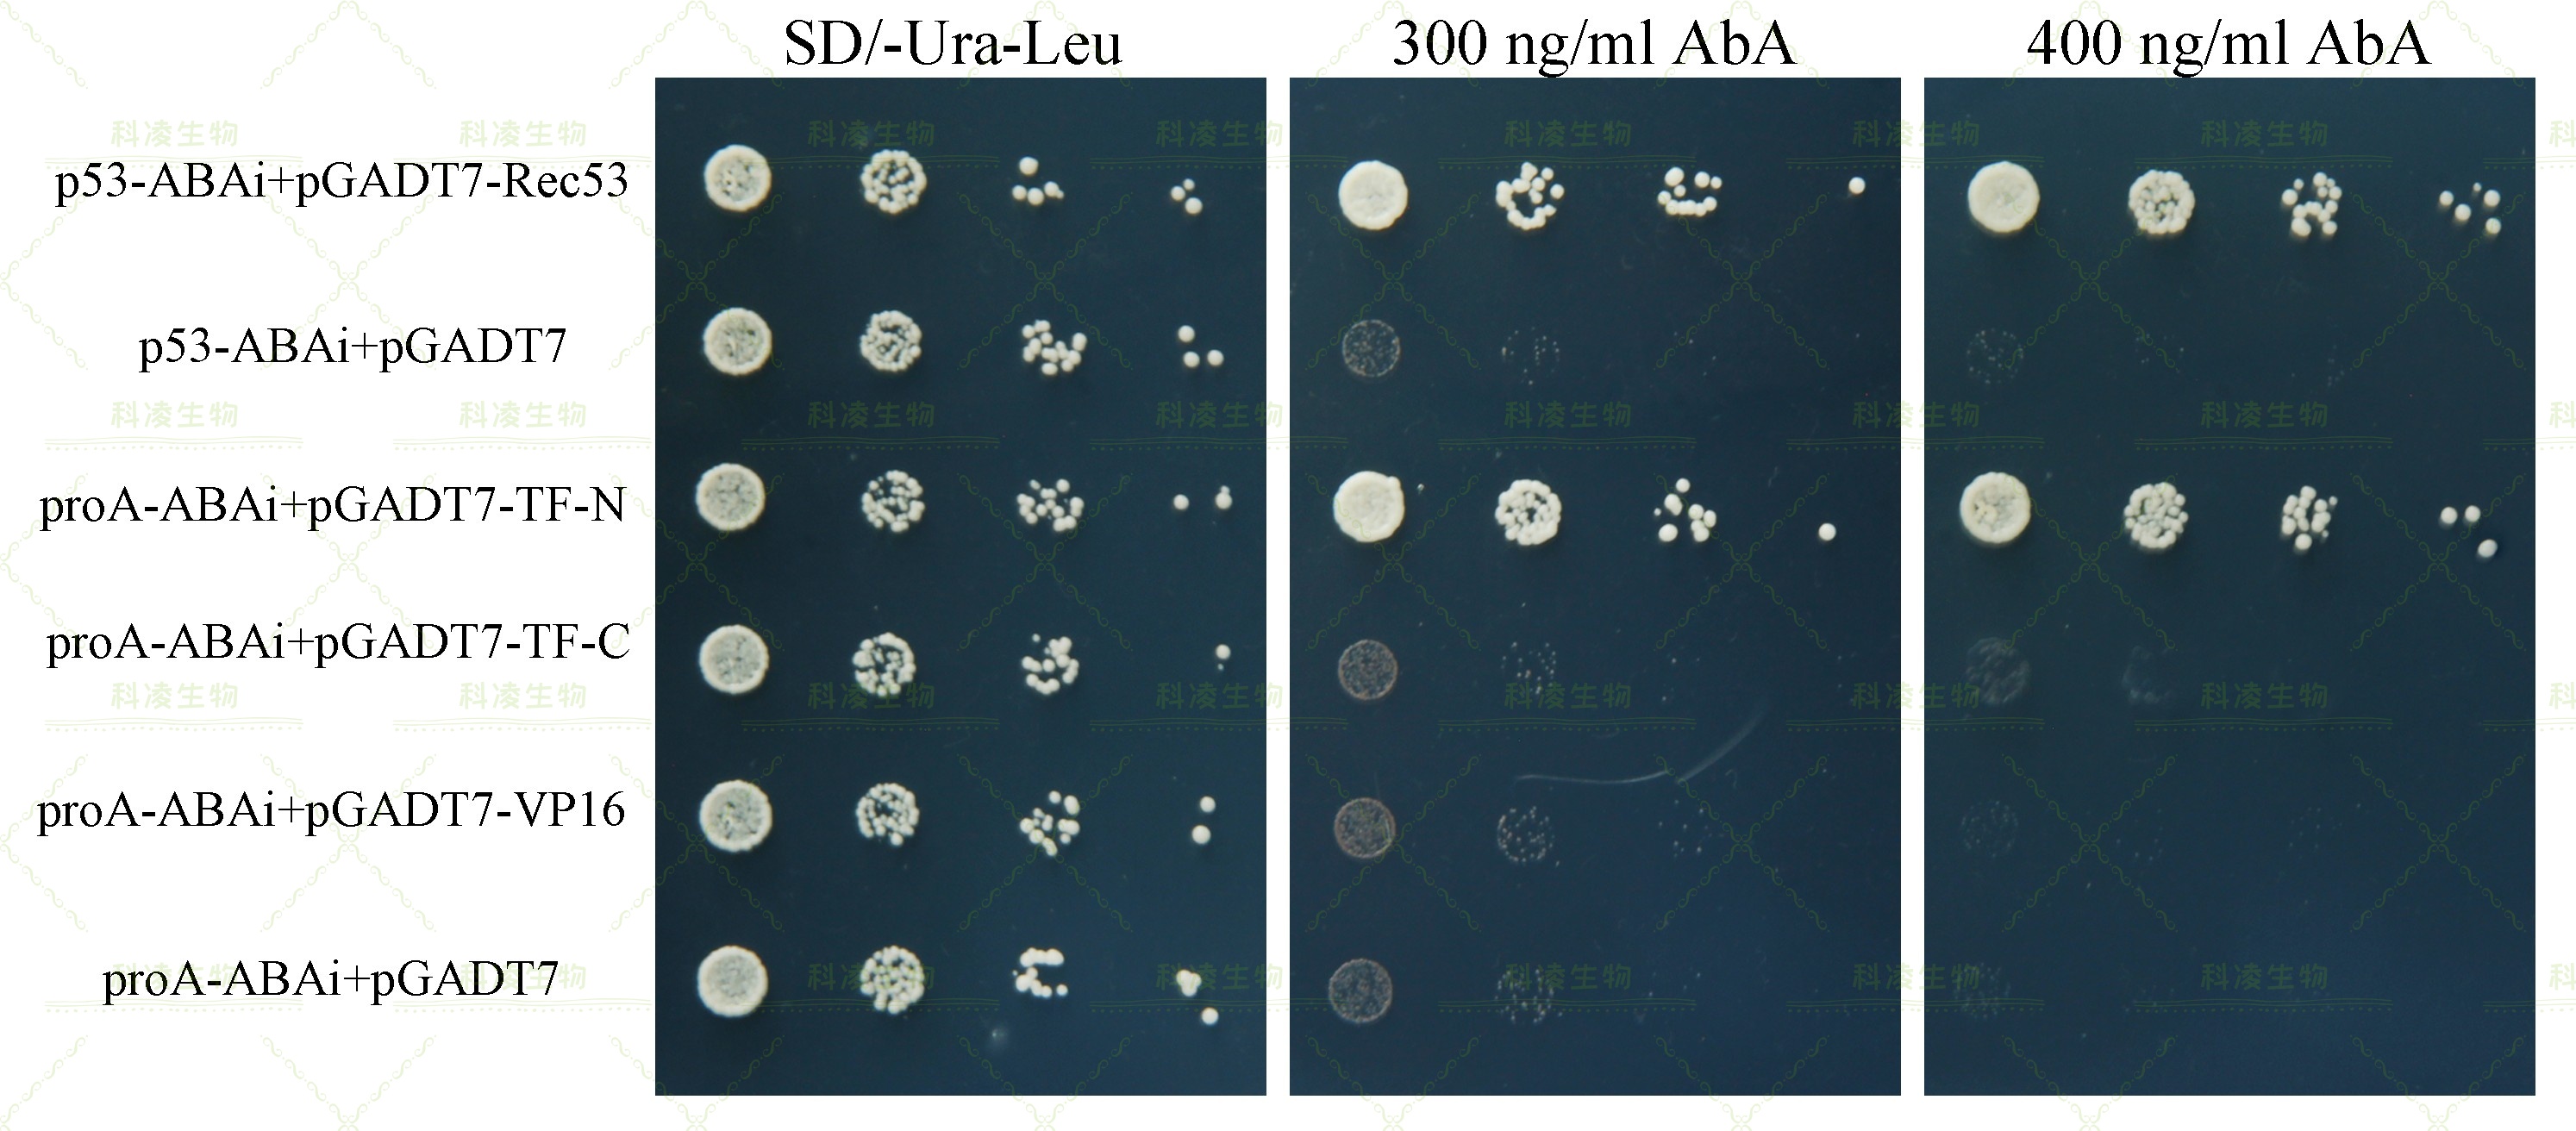
18单杂交2.jpg

技术服务
技术服务
酵母单杂交技术是由酵母双杂交GAL4系统改进而来,用于研究核酸-蛋白相互作用的互作检测系统。原理是将启动子序列或者顺式作用元件构建至报告基因的上游,并形成诱饵载体,相应的转录因子构建到pGADT7载体上形成猎物蛋白。当转录因子结合到顺式作用元件时会激活Pmin启动子,从而促进下游报告基因的表达,随后通过缺陷型培养基和筛选标记确认互作与否。目前,该技术主要用于研究真核细胞内顺式作用元件与转录因子或结构域的互作检测等。原理图如下:
1、检测蛋白与启动子间是否存在相互作用;
2、检测启动子中与蛋白互作的顺式作用元件;
3、检测转录因子中与启动子结合的结构域。
1、诱饵蛋白抑制剂背景严格筛选检测,消除酵母本底转录因子激活影响;
2、互作检测组克隆不同梯度稀释,同时设置对照组,确保结果真实有效;
3、本司具有两种单杂交互作检测方法,可验证酵母杂交结果。
咨询下单—实验信息确认—载体构建—背景筛选和点对点检测—结果交付。
标准实验报告,包括实验步骤与结果;
互作检测酵母梯度稀释点板图(单反拍照)。
载体需要新鲜或甘油菌液体积大于0.5 ml,冰袋运输;
质粒 DNA 体积大于20 μl,浓度不低于30ng/μl,,且主带明显无降解;
提供测序结果以及抗性;如需我司构建载体,要求详见载体构建。

结果初析:所有共转pABAi和pGADT7质粒的YIHgold酵母菌在二缺培养基上都长出了克隆,说明共转化成功。将SD/–Leu/–Ura培养基上的克隆挑取至含有不同浓度AbA的SD/–Leu/–Ura培养基中生长,具体结果为: 除了阳性对照转化酵母克隆可以在不同浓度的AbA中正常生长外,TF1+proA和TF2+proA共转化检测组也可以长出克隆,而TF3+proA检测组酵母克隆不能生长,说明TF1和TF2与proA序列结合的可能性较大,而TF3与proA序列无结合。
结果初析:转录因子TF与proA序列存在结合作用,为了确认转录因子与启动子结合的序列和结构域,对TF进行序列截短并与VP16形成融合蛋白,随后进行点对点检测。结果显示TF的N端序列可以结合proA序列,而C端序列无法结合启动子序列。